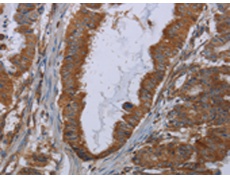
一抗

技術(shù)規(guī)格
|
Background: |
The protein encoded by this gene is highly similar to the protein product encoded by gene INSIG1. Both INSIG1 protein and this protein are endoplasmic reticulum proteins that block the processing of sterol regulatory element binding proteins (SREBPs) by binding to SREBP cleavage-activating protein (SCAP), and thus prevent SCAP from escorting SREBPs to the Golgi. |
|
Applications: |
ELISA, IHC |
|
Name of antibody: |
INSIG2 |
|
Immunogen: |
Fusion protein of human INSIG2 |
|
Full name: |
insulin induced gene 2 |
|
SwissProt: |
Q9Y5U4 |
|
ELISA Recommended dilution: |
1000-2000 |
|
IHC positive control: |
Human esophagus cancer and human brain |
|
IHC Recommend dilution: |
25-100 |


 購物車
購物車 幫助
幫助
 021-54845833/15800441009
021-54845833/15800441009